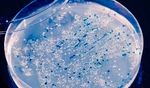
The future of Health Care - Potential, impacts and models of 3D printing in the Health Care sector - Deloitte

The future of Health Care - Potential, impacts and models of 3D printing in the Health Care sector - Deloitte
←
→
Page content transcription
If your browser does not render page correctly, please read the page content below
Contents Deloitte’s Health Care Med Tech Community 3 3D printing in Health Care 5 3D printing application models in the Health Care sector 7 3D printing in the world 9 3D printing in Italian Health Care 13 3D printing Industry Foresight 17 Conclusions 27
The future of Health Care | Potential, impacts and models of 3D printing in the Health Care sector
Deloitte’s Health Care
Med Tech Community
In 2017 Deloitte gave life to the Health Care Med In fact, 3D printing has been present in many
Tech Community, the first community dedicated economic sectors for some time and it has always
to disruptive technologies and open oriented to been one of the main areas of application in
health care and life sciences companies, scientific healthcare of great extent: the first example of 3D
associations, disruptive technology experts, printing in the health sector goes back to the first
in-house companies, purchasing centers, health half of the eighties of the last century. At that time,
care agencies, the research community, start-ups, Chuck Hall made an eye wash cup using stereo
venture capital companies, business incubators and lithography (a method to produce solid objects from
accelerators, third sector. successive hardened layers of liquid polymer).
Innovation in Health Care is the topic on which During its first year of activity, the Community
the Community is focused. Orienting the health dedicated itself to 3D printing to explore some
ecosystem towards innovation means laying the aspects: the employment models, state of the art
foundations for a transformation of the entire and worldwide diffusion, the presence in the Italian
sector, where the value is generated by the healthcare sector, the possible developments and
involvement of all stakeholders with their different barriers to overcome to bring this technology from a
points of view, perspectives and roles. Today, niche dimension to the mainstream.
more than in the past, disruptive technologies
The work of the Community has been developed
can represent the pivot of the transformation and
with the contribution of an Advisory Board
the innovation of operating models in the clinical,
representing the main stakeholders of the health
welfare, organizational and managerial fields. 3D
eco-system: hospitals, life sciences companies,
printing, augmented reality, Internet of Things
scientific associations and supply chain players.
(IoT), Big Data are just some of the technologies
currently available on the market and ready to use,
which create development and enable new ways of
interactions in the ecosystem, making it accessible
to new subjects and attractive for new investments.
The Med Tech Community format, although aware
of the natural interactions and influences among the
different disruptive technologies, aims to focus on
one technology at a time. As a starting point, in the
first year of life, the Advisory Board has decided to
start from the oldest of the innovative technologies:
3D printing.
3Figure 1 - The Advisory Board members of the Health Care Med Tech Community
Stefano Marchese Commercial Director
Smith&Nephew
Gianluca Ruffi Strategic Marketing and Market Access Director
Medtronic Guido Beccagutti Value, Access & Policy Director
Nicolò Pestelli Programme Director at Area Vasta Sud Est Toscana
ESTAR
Stefano Vezzosi Director of Informatics and Health Technologies
Intercent-ER Alessandra Boni Director
Coordinator, Office of International Relations and the Promotion of
Meyer Pediatric Hospital Kathleen McGreevy
Innovation
Fabio Galbusera Head of the Laboratory of Mechanics of Biological Structures
Istituto Ortopedico Galeazzi
Gloria Casaroli Research Engineer
Director, Research Center in Health Economics & Health Care
LIUC Università Cattaneo Davide Croce
Management
Innogest Claudio Giuliano Partner
PLS Educational Luigi Cammi Managing DirectorThe future of Health Care | Potential, impacts and models of 3D printing in the Health Care sector
3D printing in Health Care
Some analysts’ forecasts for 2018 suggest a global 3D printing is a production mode,
market growth to $12 billion, an increase of about
20% over the previous year1. In 2018, over 50% also called additive manufacturing,
of the market will be located in the United States which allows the fabrication of objects
and Europe with a turnover of $7.6 billions. Other
(component parts, semi-finished
estimates predict that the turnover will reach $20
billion by 2021 with a 20.5% compound annual or finished products) through the
growth rate, on a five-year basis, from 2017 to aggregation of successive layers of
20212. These data clearly show the dynamic growth
of 3D printing, which is emerging as a widespread
material that are added to each other. 2
technology in various market sectors.
A significant share of worldwide turnover in the 3D
printing industry has always been generated in the
medical field. In 2012, according to a study by Deloitte
University, 16.4% of 3D printing business in the US was In recent years, 3D printing applications have become
generated by the healthcare sector. Analysts forecasts increasingly more common. The 3D printing technology
that in 2018 the 3D printing worldwide turnover related has already made it possible to print surgical
to healthcare will reach $ 1.3 billion1. instruments such as hemostats, forceps, scalpel
handles, etc.3 In the next years, a quantitative increase
Different applications in the medical field support
in the established applications is expected, but also
this growth. To date, the most significant applications
the development of new applications in even more
refer to the production of different types of devices in
ambitious areas.
the dental, orthopedic and acoustic fields. However,
even the most innovative areas such as the 3D Ultimately, 3D printing technology has the potential
printing of tissues, organs and bones show important to deeply modify the healthcare’s delivery and
growth rates and begin to spread significantly (56.6% organization models in different areas of clinical
compound annual growth rate, on a five-year basis, specialization.
from 2017 to 20211).
1. 3D printing spending is about $ 12 billion in 2018, 3DPrinting.com
2. ASTM International, Standard terminology for additive manufacturing technologies, designation F2792 − 12a, 2013, p. 2
3. The Major Milestones Of 3D Printing In The Medical Industry, 3DPrintersBay.com
5The future of Health Care | Potential, impacts and models of 3D printing in the Health Care sector
3D printing application
models in the
Health Care sector
Based on some Deloitte University The integrated reading of these two Path I: stasis
research highlights on additive dimensions generates four possible
In this model 3D printing is used
manufacturing, 3D printing contributes models of 3D printing application in the
to generate efficiency rather than
to the health sector transformation health sector, as can be seen in Figure
innovation. Organizations (predominantly
by acting on two different dimensions: 2, and it allows us to develop an organic
medical device manufacturers) consider
product innovation and process and coherent approach to the analysis
3D as the acceleration technology of
innovation, the latter with particular of the opportunities of 3D printing
some processes. The most frequent
reference to traditional supply chain ("3D Printing Health Care Industry
case of using this model is related to
activities. Framework").
the use of 3D printing for the rapid
prototyping of medical devices that are
then produced on a large scale with the
Figure 2 – 3D Printing Health Care Industry Framework traditional technologies.
High product change Example
+ In early 2018, the Marchesini Group
Path III: Path IV: business
product evolution model evolution Company from Bologna, a leading
packaging manufacturer in the
Companies benefit from Companies create a new business
leveraging the 3D printing model through 3D printing pharmaceutical sector, inaugurated a
economies of scope to (e.g. bioprinting, custom new structure dedicated to 3D printing
achieve greater levels of production of implantable technology, which is, according to the
performance or innovate prostheses)
company, "one of the main declension
High supply chain change
their products (e.g. 3D printing
No supply chain change
for more precise and less of the Industry 4.0 paradigm"4. The new
invasive surgical operations) structure will be equipped with several 3D
printers, along with new systems that will
- + be working operating 24 hours a day to
quickly print prototypes for components
Path I: stasis Path II: supply chain
evolution that will then be produced through
traditional manufacturing processes. This
Companies do not look for Companies benefit from
radical changes either in the leveraging the economies of new 3D printing facility by Marchesini
supply chain or in the products. scale offered by 3D printing Group will allow customers to monitor
This type of companies use in terms of supply chain error management, machine wear and
the 3D technology to streamline (e.g. on-site production of
processes (e.g. prototyping) production planning, besides controlling
surgical equipment)
costs.
-
No product change
4. Marchesini Group Increases Focus on Industry 4.0 by Acquiring Vision System Company and Opening 3D Printing Facility, 3DPrint.com
7The future of Health Care | Potential, impacts and models of 3D printing in the Health Care sector
Path II: supply chain evolution Path III: product evolution Path IV: business model
evolution
This model can be summarized with This model is driven by the possibility of
the "manufacturing at point of use" using 3D printing to create innovative This model is the most disruptive,
paradigm. Organizations benefit by products and improve the quality of because it combines process innovation.
producing goods for healthcare use medical performance, which is going It also allows to change the supply chain
through 3D printing at the place of use to affect the generated outcome. This structure and innovate products and the
or immediately nearby. Medical devices’ is the case, now quite frequent, of the health services offered to patients. This
manufacturers, but also hospitals, could reproduction of organs and anatomical is an example of a “mass customization
have considerable advantages from the parts for the preparation of surgical at point of use”, or mass customization
application of this model. The former interventions of particular complexity in which it is possible to produce
could reduce production costs, product concerning, for example, the removal customized products (eg: implantable
delivery time, streamlining distribution of tumor masses. In other cases, it prostheses) near the place of use.
and logistic processes. End users could went so far as to realize scaffolds for The application of this model deeply
decide to create their own hubs (or to cell cultivation aimed at reconstructing modifies the business models and allows
resort to private hubs) for 3D printing anatomical parts. new ones to emerge, with potentially
inside the hospital, or for a group of relevant effects for all the supply chain
Example
hospitals, and dedicate themselves to stakeholders.
producing some devices "on their own". At the National Tissue Engineering
Example
Research Center of China, a team of
Example
scientists has released a new study A research team from the University of
The London-based company 3D describing the use of 3D printing in Glasgow used 3D printing technology
LifePrints has launched a project an ear reconstruction surgery for five to synthesize any compound to
to create "innovation hubs" on 3D children (between 6 and 9 years old) with produce pharmaceuticals. This new
printing in four National Health Service unilateral microtia. The extraordinary mode of production is a key step
(NHS) hospitals and has recently nature of this event consists in having for the digitization of chemical and
invested £ 500,000 to expand its 3D reconstructed, thanks to 3D printing, pharmaceutical manufacturing as it
printing center network and recruit the anatomical parts directly using the could allow the production of “on-
biomedical engineers and specialized 3D children’s cells. Researchers first took demand” and customized drugs, based
technicians. The company incorporated detailed CT scans of each patient’s on the needs and the clinical picture of
four "innovation hubs" on 3D printing: healthy ear, and used a 3D design individual patients. 7
three in Liverpool and one in Oxford. software to mirror the images and
Each innovation hub is a place where convert them into a 3D printable mold.
doctors, surgeons, companies and Next, cartilage-producing chondrocyte
technicians can collaborate and find cells were derived from each patient’s
new solutions for clinical and assistance malformed ear tissue, seeded onto the
problems starting to produce medical scaffold molds, and cultured for three
devices with a "manufacturing at point- months. When the cultured cartilage
of-use" approach. 5 framework had finished growing into
the shape of the patient’s ear, plastic
surgeons implanted the engineered
ear implants and performed ear
reconstruction surgery. 6
5. 3D Lifeprints Secures £500,000 Investment To Rapidly Expand, 3DLifePrints.com
6. Five Children Receive Ear Implants Made From Their Own Cells, Thanks to 3D Printed Molds and Scaffolds, 3DPrint.com
7. Chemical MP3 Player Can 3D Print Pharmaceuticals On-Demand from Digital Code, 3DPrint.com
8The future of Health Care | Potential, impacts and models of 3D printing in the Health Care sector
3D printing in the world
The Health Care Med Tech Community analyzed and then we ranked the 218 successful cases within
over 1,000 experiences from all over the world the 3D Printing Health Care Industry Framework.
regarding innovations in the use of 3D printing
The Figure 3 shows a graphical representation about
for Health Care, selecting the most significant 218
the origin of the successful experiences, reporting
cases. In particular, all the experiences that focused
the corresponding numbers for each country.
on mere prototyping (Path I: stasis) were excluded,
Figure 3 - Map of the most relevant news from the world
1 1 4
1
3 7
9 1
10
4
3
3
28
103 2
2 2
1 1
2
1
2
8 3 1 1
1 2 11
9The future of Health Care | Potential, impacts and models of 3D printing in the Health Care sector
Figure 4 - International trends in 3D printing use From the analysis of these experiences,
High product change we have identified some international
+
trends in the use of 3D printing,
Path III: Path IV: business model highlighted in Figure 4. In particular, most
product evolution evolution
of the experiences are included in Path
III and IV of the Industry Framework:
41% 51% product evolution (41%) and business
High supply chain change
No supply chain change
model evolution (51%).
- + Analyzing the trends for each country,
we highlight a leading role of the United
States (Figure 5), which shows 103
8% successful cases, 54 of which refer to
the "Path IV: business model evolution".
Even Europe and its Member States are
Path I: stasis Path II: supply chain moving in the same direction.
evolution
-
No product change
Figure 5 - Focus on trends for each country
110
103
100 Legend
90 Business
Product
model
evolution
evolution
80
70
Supply
Stasis chain
60 evolution
50
40
30
28
23
20
10 10 9 8 7
10
4 4 3 3 3 3
0
Other
10The future of Health Care | Potential, impacts and models of 3D printing in the Health Care sector
Starting from the database, we have selected 10 particularly significant cases, as reported in Figure 6.
Figure 6 - The 10 most successful international cases selected by Deloitte
San Draw Medical Introduces New
Quebec: New Research Center for 3D
Accuracy with 3D Printed Suture
Printing Solutions.
Simulator.
Materialise Expands DePuy Synthes
Wrap, the 3D Printer Plaster that Halves
Partnership to Design New 3D Printed
Healing Times.
Surgical Guides.
QMUL Researchers Use 3D Printing and
EIT 3D Printed Cellular Titanium Spinal
Self-Assembly Technologies to Create
Implants Receive FDA Clearance.
Constructs Using Cells and Molecules.
RegenHU and Wako Automation Five Children Receive Ear Implants Made
Promoting Drug Discovery and 3D from Their own Cells, thanks to 3D Printed
Bioprinting in the US. Molds and Scaffolds.
A 3D Printer Can Print Pharmaceuticals
T3Ddy Laboratory is Born at the Meyer
On-demand from Digital Code in
Pediatric Hospital.
Glasgow.
At the Italian level, the experiences of the M3datek startup and the Meyer Pediatric Hospital deserve a special attention
because of their innovativeness degree.
Wrap, the 3D Printed Plaster that Halves T3ddy Laboratory is born at the Meyer Pediatric
Healing Times8 Hospital9
M3datek, a start-up of the University of 3D printing enters Meyer’s clinical practice with T3Ddy,
Parma, in 2015 created WRAP (Wound the joint laboratory established with the University of
Repair Active Print), a plaster able to Florence. T3Ddy applies 3D printing in an innovative way
halve the healing time thanks to the use of for a series of highly advanced uses: from the creation
3D printing. The plaster, designed for the of three-dimensional models to improve the surgical
treatment of diabetes and bed sores, is made approach, to the realization of tailor-made plaster casts
of chitosan (a natural polymer that is found, for the limbs, in addition to the wide use in simulation in
for example, in the exoskeleton of many pediatrics for the operators training. Some pilot projects
invertebrates) and it is produced with the are particularly relevant, such as: the development of new
support of a 3D printer. In particular, the 3D medical devices for the treatment of malformations of the
structure allows patients to obtain different rib cage; the reconstruction of anatomical parts for the
benefits compared to traditional medicines: planning and execution of the most complex interventions
WRAP fits to wounds of varying size and (eg. a tumor from the cranial base has recently been
depth, it can be applied to sores in different successfully removed without touching the brain of a
stages of advancement. Moreover, the healing 16-year-old patient, thanks to a careful pre-operative
process is accelerated compared to the planning). This also brings children closer to science and
products already on the market: the healing technology. By introducing 3D technologies into the clinical
times are halved, going from 15 to 7 weeks. practice, T3Ddy lays the foundation for the standardization
of the procedures for the construction of personalized
medical devices.
8. Wrap, the 3D Printed Plaster that Halves Healing Times, ParmAteneo.it
9. T3Ddy Laboratory is born at the Meyer Pediatric Hospital, Meyer Pediatric Hospital Institutional Website
11The future of Health Care | Potential, impacts and models of 3D printing in the Health Care sector
3D printing in
Italian Health Care
To understand the state of the art on Figure 7 - Survey respondents
the diffusion of 3D printing within the
Italian healthcare sector, we conducted
a survey of the main stakeholders of the
48% Hospitals
health ecosystem: hospitals, life sciences
companies, supply chain players,
scientific associations. The survey,
sent to a hundred individuals, saw the
collaboration of 50 participants, divided
into four targets as shown in Figure 7.
The survey dealt with 7 areas of 22% Scientific associations
analysis divided into 3 clusters:
16%
1. Awareness of the potential to be
exploited. Life sciences companies
2. Actions to be taken to develop
sustainable adoption models.
14% Supply chain players
3. Barriers to overcome for large-scale
applications.
The survey showed that its respondents
see significant opportunities in 3D
technology that, of course, differ
according to the perspectives of different
stakeholders.
13The future of Health Care | Potential, impacts and models of 3D printing in the Health Care sector
Figure 8 - Opportunities for hospitals The hospitals recognize great potential
in different fields and, in particular, in the
Reconfiguration of the relationship with
medical devices suppliers
personalization of treatments (i.e. tailor-
made prostheses) and in the creation
Creation of print centers
in the single hospital of public hubs at regional or supra-
Creation of public hubs at regional company level.
and/or wide area level
Creation of private hubs
Innovation of diagnostic and
surgical techniques
Real-time printing of medical devices
(implantable and non-implantable)
Personalization of treatments
Reduction of costs for the purchase/
logistics management of medical devices
0% 2% 4% 6% 8% 10% 12% 14% 16% 18%
Figure 9 - Opportunities for supply chain players The personalization of treatments is one
of the greatest capabilities of 3D printing
also for supply chain players, along with
Creation of private hubs
the reconfiguration of the relationship
Creation on public hubs at regional with medical devices suppliers from a
and/or wide area level
product-based logic to a service one.
Possibility to produce medical
devices independently
Reconfiguration of the relationship with
medical device providers, from a product
logic to a service approach or a generated
value sharing for the patient
Real-time printing
Personalization of treatments
Innovation of diagnostic and
surgical techniques
0% 5% 10% 15% 20% 25% 30%
Figure 10 - Opportunities for life sciences companies In addition to the personalization of
services for the patients, life sciences
companies also envision the possibility of
Reconfiguration of the relationship
with Regions and Hospitals reconfiguring the relationship between
Regions and the Health Authorities,
Market entry of new adopting a service-oriented approach
unconventional competitors
rather than a product-oriented one.
They also foresee some possible
Possibility to offer increasingly personalized
and patient-oriented services threats coming from the entry of new
non-conventional players into their core
0% 5% 10% 15% 20% 25% 30% 35% market.
14The future of Health Care | Potential, impacts and models of 3D printing in the Health Care sector
All respondents, in addition to the Figure 11 - The barriers to the diffusion of 3D in the healthcare system
potential, also report the presence of
Degree of agreement per target
some barriers that limit a large-scale
spread of 3D printing. Life sciences Scientific Supply chain
Hospitals companies associations players
The main obstacles can be found in the
lack of regulation, especially since the 43% Lack of regulation on the 3D printing
production process
subject is not included in the Medical
Devices Regulation (EU) 2017/745, and
24%
Lack of knowledge and skills on the
use of technology and the related
in the technology adoption, both in organizational models
terms of knowledge about printers and
materials available for printing, as well as
Uncertainty about the amount of
in terms of internal skills to be developed
and amount of investments to be 24% investments in technology required
by the company and the related
economic return
undertaken.
The large-scale adoption of 3D printing
9% Maturity of technology (performance
of printers and materials available)
is characterized by the combination of
“high potential/ high barriers”. If, on the High Moderate Low
one hand, there is a strong awareness
of the potential of this technology, on
the other hand the missed mainstream
diffusion of 3D technology is attributed
to the presence of many regulatory and
technical obstacles that have prevented
its exponential growth.
15The future of Health Care | Potential, impacts and models of 3D printing in the Health Care sector
3D printing
Industry Foresight
Methodology Figure 12 - The Industry Foresight methodology applied to 3D printing
The survey identified the two main
drivers in the technological and 1. Driver
regulatory dynamics on which the
The starting point is represented
evolution of 3D printing in the health
by the main drivers emerging from
sector will depend.
the eco-system survey: regulation
To imagine the possible future scenarios and technology.
for 3D printing in healthcare, two
possible trends were analyzed for
each driver: the optimistic one and the 2. Trend
pessimistic one.
For each driver, we have identified
From the analysis of possible some possible future trends by
combinations, four different scenarios imagining two visions: one optimistic
about the future of 3D printing have (+) and one pessimistic (-).
been articulated, within a 5 and 10 year
time-span.
3. Scenarios
These scenarios, with their
corresponding impacts on the main Based on the identified trends, we
stakeholders in the eco-system hypothesized four possible scenarios
(healthcare providers, patients, which are the result of the convergence
life sciences companies, scientific of the visions of the two drivers.
associations, purchasing groups
and supply chain players), have been
discussed with the Advisory Board 4. Impacts
members.
These scenarios have been declined
on the individual stakeholders of the
health ecosystem to understand the
possible impacts.
17The future of Health Care | Potential, impacts and models of 3D printing in the Health Care sector
Trends: the dynamics of technology and the regulatory system
Figure 13 - Possible trends in the future evolution of 3D printing technology
+ The new R&D research and investments in the 3D printing sector will lead to developments
and innovations along two directions: on the one hand, the availability of biocompatible
materials with high performance properties will increase (e.g. mechanical properties - rigidity
and elasticity); on the other hand, more performing and multi-material printers will be
developed in line with the timing of health providers. Therefore, the technology providers will
begin to produce printers that will be more technically performable in order to quickly create
objects that can be customized with respect to the patient's clinical picture, as well as generic
objects (orthopedic tools) or drugs. All these factors will lead to a market structure characterized
by the presence of vendors that will make 3D printing competitive, economically and
Technology
qualitatively, compared to traditional methods of medical device production. This will
entail the possible entrance of new players within the life sciences and medical device sector
and will impact the entire supply chain (e.g. the creation of local hubs for sorting and supply of
materials), also giving access to the self-production of medical devices.
The technology will evolve, but not quickly and – anyway - not to the point of allowing
significant technological leaps. In particular, we will not invest much in the search for
biocompatible materials aimed at the production of implantable prostheses. From a technical
point of view, printers will not be upgraded, significantly limiting the possibility of realizing
- realistic devices in a short time. In particular, high productivity printers will not establish
themselves on biocompatible materials and the multi-materiality will be limited.
Figure 14 - Possible trends in the future evolution of regulation on medical devices printed in 3D
In the perspective of giving a new impetus in regulatory terms, the Food and Drug Administration
+ (FDA) will continue to set standards for the production process of the 3D printed devices and
will end up defining a regulatory framework where some aspects are clearly defined, such as the
design of the devices, the functionality-based product testing system, the duration and the quality
system requirements. The European institutions will also start moving in the same direction. The
new European Regulation for medical devices will be integrated with specific standards for 3D
printed devices. The evolution of regulation will also concern 3D printed drugs and the materials
Regulation
used for printing. Thanks to this regulation, the production of 3D printed products will increase
not only in quantitative terms, but also in terms of diversification of the usage areas, with a strong
expansion of the potential market.
The institutions at international level will limit themselves to set production standards only
for some sectors, introducing limits to the production chain. There will be no major progress,
and what today is not regulated because of its limits and regulatory gaps will continue not being
-
so also in the future, especially in Europe. The absence of a clear and structured regulation of
the production of 3D printed devices will continue to limit the mainstream applications of this
technology.
18The future of Health Care | Potential, impacts and models of 3D printing in the Health Care sector
The four future scenarios of 3D printing
From the conjoint/combined analysis of the future trends, it is possible to identify four
possible scenarios about 3D printing in health sector.
Scenario 1: Underground
- -
This scenario will be characterized by a reference to the medical sector, in the
regulatory framework that at global European market such technologies
level will continue to favor the use could be unavailable, unusable or too
of materials and technologies for 3D expensive, with regard to the possible
printing. The intensity of this regulatory uses deriving from the configuration of
dynamic, especially in the European the regulatory context and the lack of
Union and its Member States, however, adoption models, investment capacity
will have an incremental nature and a and competent professional figures in
limited impact. the hospitals.
The European Medical Device The absence of significant uses in a
Regulation 2017/745, entered into force market like Europe could influence the
on 25 May 2017 and exclusively applied availability of new materials and new 3D
from 26 May 2020, will not significantly printing technologies for the medical
integrate the 3D printing sector in the sector on a global scale.
implementing acts.
The EU will deal with 3D printing in
a residual manner with regard to
specific cases, leaving the primacy in
this regulatory framework to FDA
(Food and Drug Administration), which
in 2017 was the first global regulatory "It seems to me very likely that the use of
authority to publish a guideline 3D printing for education and preparation
on 3D printing of medical devices
("Technical considerations for additive
of complex surgical procedures will
manufactured medical devices"). establish itself over the next few years." *
The technologies and materials for 3D Fabio Galbusera,
printing will grow exponentially in the Head of the Laboratory of Mechanics of Biological Structures at
coming years. However, with specific IRCSS Istituto Ortopedico Galeazzi
* Statement issued in a personal capacity and not representing the company to which it belongs.
19The future of Health Care | Potential, impacts and models of 3D printing in the Health Care sector
Scenario 2: Regulatory Driven niche
+ -
This scenario will be characterized by due to resistance factors and internal
a regulatory framework, which will barriers to health systems. In particular,
make possible the maximum level of there may be problems related to the
use of materials and technologies for 3D availability of financial resources deriving
printing. from the growing pressure that the
demographic dynamics are putting
At regulatory level, the FDA will make
on many western health systems; the
3D printing one of the first areas
difficulty of defining and activating
of interest, if not the first one, by
3DP-based operational models on a
exponentially increasing its interventions
large-scale for organizational reasons;
in this field. The European Union will
an insufficient availability of skills and
move in the same direction, adopting
specialized professional figures within
a regulatory framework where it will
the hospitals. Moreover, in the public
be possible to print many types of
sector, some procurement models that
devices (even directly in hospitals or
are not effective in acquiring innovative
in pharmacies), including those of an
solutions could further slow down big
implantable type as well as a large
projects. In this scenario manufacturers
number of drugs.
and hospitals will use 3D printing with a
In the coming years, the technologies “by default” logic, but they will do so only
and materials for 3D printing will grow in specific areas of proven effectiveness
exponentially, but the applications and efficiency, depending on their overall
in the healthcare sector will not readiness and profitability. In other
grow proportionally. Consequently, words, several niches focused on the
the diffusion of 3D printing will be use of 3D printing will come up in those
lower than that recorded by other clinical contexts that currently prove to
sectors in which it will become be the readiest or most promising in
mainstream. This will mainly occur adopting this technology.
20The future of Health Care | Potential, impacts and models of 3D printing in the Health Care sector
Scenario 3: Technology Driven niche
- +
This scenario, which is the opposite of inability of operators to adopt 3D printing
the previous one, will be characterized technologies, but rather by the inability
by a technological structure in of doing so in a greater number of areas
continuous evolution, pushing the and with greater regulatory certainty. In
health eco-system stakeholders towards other words, some niches of 3d printing
an ever-increasing use of 3D printing, use will consolidate in the clinical areas
also through the development of that are already common today. They will
adequate organizational models and be based on the consolidation of the “by
skills. default” logic through applications and
processes already available and, in some
The technologies and materials will
cases, established.
lead to significant developments in
all fields of 3D printing application.
The availability of biocompatible
materials with high performance
properties will increase (e.g. mechanical
properties: rigidity and elasticity); and
faster and multi-material printers
will be developed, in line with the timing "Probably the 3D printer will increase in-
of healthcare providers. The costs of
home usage, but I do not think it will be
technology will decrease, and will make
3D printing ever more accessible and used for health purposes. For example,
available. the production of first-aid devices would
The regulatory framework, however, require materials and sterilization that
will not have a similar development
since it will have the same dynamics
could lead to a substantial increase in
already described in the underground costs, thereby disadvantaging the in-
scenario. The epilogue of this scenario home production." *
is similar to the previous one, because
the result will be a niche market that, Gloria Casaroli,
however, will not be determined by the Research Engineer at Istituto Ortopedico Galeazzi
* Statement issued in a personal capacity and not representing the company to which it belongs.
21The future of Health Care | Potential, impacts and models of 3D printing in the Health Care sector
Scenario 4: Mainstream
+ +
The last scenario is the most disruptive. healthcare sector. A regulatory framework
In this possible future, technological and will be available, defining the production
regulatory dynamics will push many fields standards, the design of the devices
of application of this technology towards and the quality requirements for the
models of 3D printing “by default”, where creation of medical devices, drugs and
3D printing for the production of drugs, artificial organs, with all the 3D printing
devices and health materials becomes techniques.
an ordinary model. As such, it also
radically changes the business models
of both those providing health care as
well as those providing services to such
providers.
In the coming years, technologies and
materials for 3D printing will reach
"In the medium term, thanks to the
exponential developments that are not lowering of costs, many of the big players
fully predictable today. 3D printing will will move from the current "subtractive
become mainstream, spreading in every
hospital, and there will be specialized
technology" to the "additive" 3D printing
technicians operating in many facilities. technology. The possibility of relocating
The 3D printing will significantly favor
production, of course, will drastically
the diffusion of a customized medicine,
thanks to the possibility of a fast and change the way of conceiving the supply
precise printing. chain. The relocated production will
Even the most complex applications such become a real commercial offer, where
as transplants with artificial 3D-printed
organs will be possible and will bring a
the company will sell the plant of a
significant contribution to the cure of printing center for the hospital, instead
many diseases, also putting an end to of the single piece (prosthesis), with
unpleasant and ethically unacceptable
exploitations. the exploitation of some proprietary
All of this will be possible also because
patents (design) of plants, and the
of the regulatory framework that will associated services including labor for its
favor the use of 3D printing in all its
functioning." *
applications. The European Union and
its Member States will also firmly push Gianluca Ruffi,
the application of 3D printing in the Strategic Marketing Director at Smith & Nephew
* Dichiarazione rilasciata a titolo personale e non in rappresentanza dell’azienda di appartenenza.
22The future of Health Care | Potential, impacts and models of 3D printing in the Health Care sector
Impacts on health stakeholders
The identified scenarios were articulated on the individual stakeholders of the health eco-system (healthcare providers, patients,
life sciences companies, scientific associations, purchasing centers and supply chain players) to understand their possible
impacts. For each of them, the Advisory Board of the Health Care Med Tech Community contributed in identifying the relative
probability of occurrence in a period between 5 and 10 years. The impacts in the various scenarios are shown below.
Figure 15 - The underground scenario and the Advisory Board’s opinion
- - Probability of occurrence
Somewhat
Stakeholder Impact Unlikely Very likely
likely
Health care techniques and processes will not evolve significantly, 3D
printing will continue to be used in limited areas and will become mainstream
especially as a technique of education and preparation of complex 5 ye a r s
Healthcare surgical interventions. The promises and potential that characterize 3D
providers printing will not be fully understood, such as, for example, the production
10 ye a r s
and use by default of organs produced with biocompatible materials or the
setting up of 3D printing centers near the operating theaters for printing of
customized prostheses.
Patients will partially benefit from 3D printing. Indirectly, 3D printing will
improve, for example through the reproduction of organs for the preparation 5 ye a r s
of interventions, the outcome of a large number of surgical procedures.
Patients
However, the use of 3D printing on processes that actively involve the patient,
for example to produce customized prostheses at a distance or to print drugs
and / or devices at home, will be possible, but limited to circumscribed cases. 10 ye a r s
3D technology will continue to be used for prototyping purposes
and will only be fully utilized in areas with clear regulation. The large
5 ye a r s
Life sciences
pharmaceutical and medical device companies will not have the advantage of
companies
10 ye a r s
significantly modifying their methods of production and distribution of medical
devices (both high cost, implantable and high volume treatments).
5 ye a r s
Scientific associations and the research world will not consider 3D
printing a key topic in defining clinical studies, guidelines and protocols. A
Scientific limited number of Health Technology Assessment (HTA) studies will be linked
associations to 3D printing in an explicit way in order to grasp links between the technology
and the resulting outcome. The scientific community will not significantly push
the adoption of these technologies into its protocols and recommendations.
10 ye a r s
5 ye a r s
3D printing will not represent a significant expense item for public
aggregators and will continue to be purchased by individual hospitals. The
creation of regional press centers (for example for prosthetics) will not be
Supply chain
feasible on a large scale for regulatory reasons and consequent cost / benefit
ratio. 3D printing will not significantly change the acquisition, logistics and
distribution models of medical devices in health authorities. 10 ye a r s
23The future of Health Care | Potential, impacts and models of 3D printing in the Health Care sector
Figure 16 - The Regulatory Driven niche and the Advisory Board’s opinion
+ - Probability of occurrence
Somewhat
Stakeholder Impact Unlikely Very likely
likely
Some health care techniques and processes will evolve significantly and
3D printing will establish itself as a reference mode (3DP by default), even
within limited areas and will definitively establish itself as a standard for
5 ye a r s
Healthcare education activities and preparation of complex surgical interventions.
providers Only some of the promises and potential that characterize 3D printing
10 ye a r s
will be captured, due to the limited interest of the suppliers of technologies
and materials to develop in a generalized way all the application opportunities
deriving from the opening of the regulatory framework.
Some patients will benefit significantly from 3D printing, depending
on the niches in which it will become a standard. For these patients, the
development of techniques based on the use of 3D could lead (depending
on the attractiveness of the reference area) to different types of benefits and
5 ye a r s
improve the outcome of the care received and the experience of using the
Patients
service, thanks to factors such as: the availability of tailor-made prostheses, the
reduction of waiting lists in relation to even serious and chronic diseases (e.g. a
dialysis patient waiting for transplantation), the possibility of obtaining services
at a distance (e.g. of a custom prosthesis in rapid time by a remote scan) or -
10 ye a r s
on the contrary - in hospital in real time.
5 ye a r s
3D technology will continue to be used for prototyping and fully exploited
only in areas where it is economically convenient. The large pharmaceutical
Life sciences and medical device companies will start for some products in their portfolio to
companies convert production processes and marketing mix into welfare processes that
involve the use of 3DP. New competitors, global and local, coming from non-
conventional sectors could emerge in the market. 10 ye a r s
5 ye a r s
In the definition of clinical studies, guidelines and protocols, the scientific
societies and the research world will begin to consider the 3DP in a
Scientific good number of studies of Health Technology Assessment (HTA), but they
associations will not always have satisfactory outcomes. The scientific community will
significantly push the adoption of these technologies within its protocols and
recommendations only in some areas. 10 ye a r s
3D printing will be a more relevant item of expenditure for public
aggregators. However, it will continue to be purchased by individual
hospitals. Centralized tenders at regional and / or national level are not 5 ye a r s
envisaged. At an embryonic level, some hospitals could start in-house printing
Supply chain
of medical devices and evaluate the possibility of rationalizing the supply chain
10 ye a r s
in relation to some products, trying to limit the use of supplies in deposit
account/evaluation which historically represent something critical within
healthcare organizations.
24The future of Health Care | Potential, impacts and models of 3D printing in the Health Care sector
Figure 17 - The Technology Driven niche and the Advisory Board’s opinion
- + Probability of occurrence
Somewhat
Stakeholder Impact Unlikely Very likely
likely
Healthcare Providers will have greater access to technology thanks to lower
costs, but the use of implantable devices printed in 3D on patients will be
limited to some types, excluding devices that require stringent regulation 5 ye a r s
(e.g. prostheses, artificial organs printed with the bioprinting techniques).
Healthcare
Although there will be technological means for the creation of Printing
providers
Centers near the operating theaters, these will not be realized on a large
10 ye a r s
scale due to the slow development of regulation in this area. 3D printing will
become mainstream as a technique of education and preparation of
complex surgical procedures.
3D printing will allow the production of customized prostheses on a large
5 ye a r s
scale (both at high cost - implantable and at high volumes - treatments), but
there will be limits to the diffusion of bioprinting. The use of 3D printing for
the preparation of surgical procedures will benefit patients by improving
Patients the outcome of numerous surgical procedures. The lower costs of the
technology will allow the purchase of printers even to patients themselves,
who will begin to produce, directly in-home, both health items that do not
require stringent regulation (e.g. pills holders, first aid kit, etc.), and non-health 10 ye a r s
objects in common use (e.g. household utensils, fashion accessories, etc.).
The commercialization of many products will still be curbed (e.g.
bioprinting) and will continue to use 3D technology for the purpose of
prototyping the device, thus becoming a consolidated practice in the
5 ye a r s
Life sciences production process; however, the main players on the market will not be
companies encouraged to move towards mass production due to the lack of production
10 ye a r s
standards. The new companies, on the other hand, will derive the
flexibility from this technology that itself allows, and will make it their core
business, thanks also to the lower costs related to the technology readiness.
The Scientific Associations will make 3D printing central in numerous
studies of Health Technology Assessment (HTA). The scientific community
will try to give voice to the main stakeholders that gravitate around the 3D
5 ye a r s
Scientific
technology carrying out activities related to research and innovation,
associations
promoting training courses to develop and consolidate the skills necessary
for the use of technology and inserting it into its own protocols and
recommendations.
10 ye a r s
5 ye a r s
Despite the best cost / benefit ratio for 3D printing and the availability of
technological resources, the creation of regional print centers will not yet
be fully feasible on a large scale for regulatory reasons. Individual hospitals
Supply chain
will continue privately to equip themselves with 3D printers for printing models
that will be used for education and simulation or some implantable, but
without resorting to the bioprinting technique.
10 ye a r s
25The future of Health Care | Potential, impacts and models of 3D printing in the Health Care sector
Figure 18 - The Mainstream scenario and the Advisory Board’s opinion
+ + Probability of occurrence
Somewhat
Stakeholder Impact Unlikely Very likely
likely
Healthcare Providers will realize in-home and in short time surgical devices
and, for this reason, they will have to acquire the necessary technology and
skills. The advent of bioprinting will allow on patients the use of implantable
5 ye a r s
Healthcare
devices printed in 3D and will lead to advances in surgical techniques and
providers
the reduction of waiting lists (e.g. waiting lists for organ transplants). They
will also benefit in terms of reduced costs for the purchase and / or logistics
management of medical devices.
10 ye a r s
The possibility of creating highly customized prostheses will allow shorter
recovery times and better biocompatibility compared to prostheses made
with traditional techniques. The perceived quality of health care received will 5 ye a r s
increase, thanks, for example, to the reduction of waiting lists that will allow
Patients
the needs of the patients to be satisfied more quickly. 3D printing will also be
10 ye a r s
accessible to the individual, thanks to its diffusion and the lower costs, which
will be able to realize in-home some objects (e.g. pencil cases, first aid kits,
etc.).
The development of 3D printing will lead to more investments in the
sector, and even the main market players will be encouraged to introduce
this technique for large-scale production. New skills will be introduced in 5 ye a r s
Life sciences companies. The presence of high performance printers from a technical
companies point of view (speed and precision), will allow the consolidation of mass
10 ye a r s
customization, the production of customizable objects in large volumes. There
will be a reconfiguration of the relationship with the Regions and the health
structures.
Universities and Scientific Associations will be involved in redesigning
university courses to develop technical skills in the 3D sector. The scientific
5 ye a r s
Scientific
associations will define new guidelines for the use of technology and will be
associations
10 ye a r s
promoters of training courses for health personnel to develop and consolidate
the necessary skills to use this technology.
5 ye a r s
Thanks to the benefits introduced by 3D printing and its diffusion, there will
be a substantial change in procurement strategies and, therefore, in the
structure of tender specifications, in a service and / or performance based
Supply chain
logic. The creation of public hubs for 3D printing at the regional level will be
promoted. These hubs will modify the supply chain making 3D printed devices
available in less time and with greater ease at the point of use. 10 ye a r s
26Il futuro dell'Health Care | Potenzialità, impatti e modelli del 3D printing in ambito sanitario
Conclusions
3D printing has been a reality in the health sector Although the awareness of the relevant 3D printing
for many years, at worldwide level as well as in potential seems to be high, among the Advisory
Italy. Until now, the regulatory framework and the Board members and the survey respondents,
technological evolution have not allowed such a way the ability of defining adoption paths and models
of production to be applied on a large scale. for these technologies reveals some points of
uncertainty. Some examples: the ways of developing
In fact, the applications of 3D printing are still
the necessary competences for the use of 3D
of interest to the media. They are newsworthy.
printing inside the hospitals; the organizational
This means that, for many years, this technology
models enabling the creation of hubs at a supra-
has been limited to a niche, which has involved a
enterprise level; the size and type of investments;
relatively small number of hospitals in a structural
the ways of reconfiguring the relationships between
manner and with a limited scope of applications. In
health companies and suppliers, especially in the
many cases, it remained in an experimental phase.
medical device sector.
During the last few years, we have witnessed
In this regard, the evolution to mainstream 3D
several changes. From a regulatory perspective, in
printing is not just a matter of market regulation,
the United States, the FDA has started focusing on
which is in any case a prerequisite (as some
3D printing more and more. Speaking of available
successful Italian cases demonstrate), but certainly
technologies, printers and materials have greatly
not a sufficient one. On the contrary, it implies
evolved.
the development of a shared and engaged call-
In the coming years, this process dealing with the to-action among all the actors in the ecosystem
regulation of 3D printing and the technological of our national health service, so as to define:
evolution of printers and materials will continue and an agenda about the priorities to deal with; the
intensify. evaluation models based on the HTA method for the
At the European level, with regard to the applications of 3D printing that are able to support
implementation path of the new Regulation for the investment programs and decisions; the
medical devices, it is desirable to recover a vision and capabilities to be developed or acquired in order to
a perspective on the 3D printing sector that have not use these new techniques with the corresponding
been considered in the original legislative text. development paths; the organizational models and
ways of reconfiguring the relationship between
In fact, with regard to the different European health companies and traditional or emergent
healthcare systems and, thus the Italian one, a great suppliers.
deal of the 3D printing evolution and development
depends on the regulatory context at the European
Community level.
In this respect, the potential envisioned by the
different stakeholders for our national healthcare
service would actually be considerable both in
terms of impact on the patients as well as of process
innovation and cost reduction.
27The future of Health Care | Potential, impacts and models of 3D printing in the Health Care sector
Bibliography
1. 3D printing spending is about $12 billion in 2018, 3DPrinting.com
2. ASTM International, Standard terminology for additive manufacturing technologies, designation F2792 −
12a, 2013, p. 2
3. The Major Milestones Of 3D printing In The Medical Industry, 3DPrintersBay.com
4. Marchesini Group Increases Focus on Industry 4.0 by Acquiring Vision System Company and Opening 3D
printing Facility, 3DPrint.com
5. 3D Lifeprints Secures £500,000 Investment To Rapidly Expand, 3DLifePrints.com
6. Five Children Receive Ear Implants Made From Their Own Cells, Thanks to 3D Printed Molds and
Scaffolds, 3DPrint.com
7. Chemical MP3 Player Can 3D Print Pharmaceuticals On-Demand from Digital Code, 3DPrint.com
8. Wrap, the 3D Printed Plaster that Halves Healing Times, ParmAteneo.it
9. T3Ddy Laboratory is born at the Meyer Pediatric Hospital, Meyer Pediatric Hospital Institutional Website
29Authors Davide Lipodio LSHC Innovation Industry Representative dlipodio@deloitte.it Veronica Colombi Senior Consultant vcolombi@deloitte.it Giacomo D'Alessandro Analyst gidalessandro@deloitte.it Verdiana Carini Analyst vcarini@deloitte.it Contacts Valeria Brambilla LSHC Industry Leader vbrambilla@deloitte.it Guido Borsani PS Industry Leader guborsani@deloitte.it
This communication contains general information only, and none of Deloitte Touche Tohmatsu Limited, its member firms, or their related entities (collectively, the “Deloitte Network”) is, by means of this communication, rendering professional advice or services. Before making any decision or taking any action that may affect your finances or your business, you should consult a qualified professional adviser. No entity in the Deloitte Network shall be responsible for any loss whatsoever sustained by any person who relies on this communication. Deloitte refers to one or more of Deloitte Touche Tohmatsu Limited, a UK private company limited by guarantee (“DTTL”), its network of member firms, and their related entities. DTTL and each of its member firms are legally separate and independent entities. DTTL (also referred to as “Deloitte Global”) does not provide services to clients. Please see www.deloitte.com/about for a more detailed description of DTTL and its member firms. © 2018 Deloitte Italy S.p.A. Graphic Department - Italy | SG.043.18C ENG
You can also read